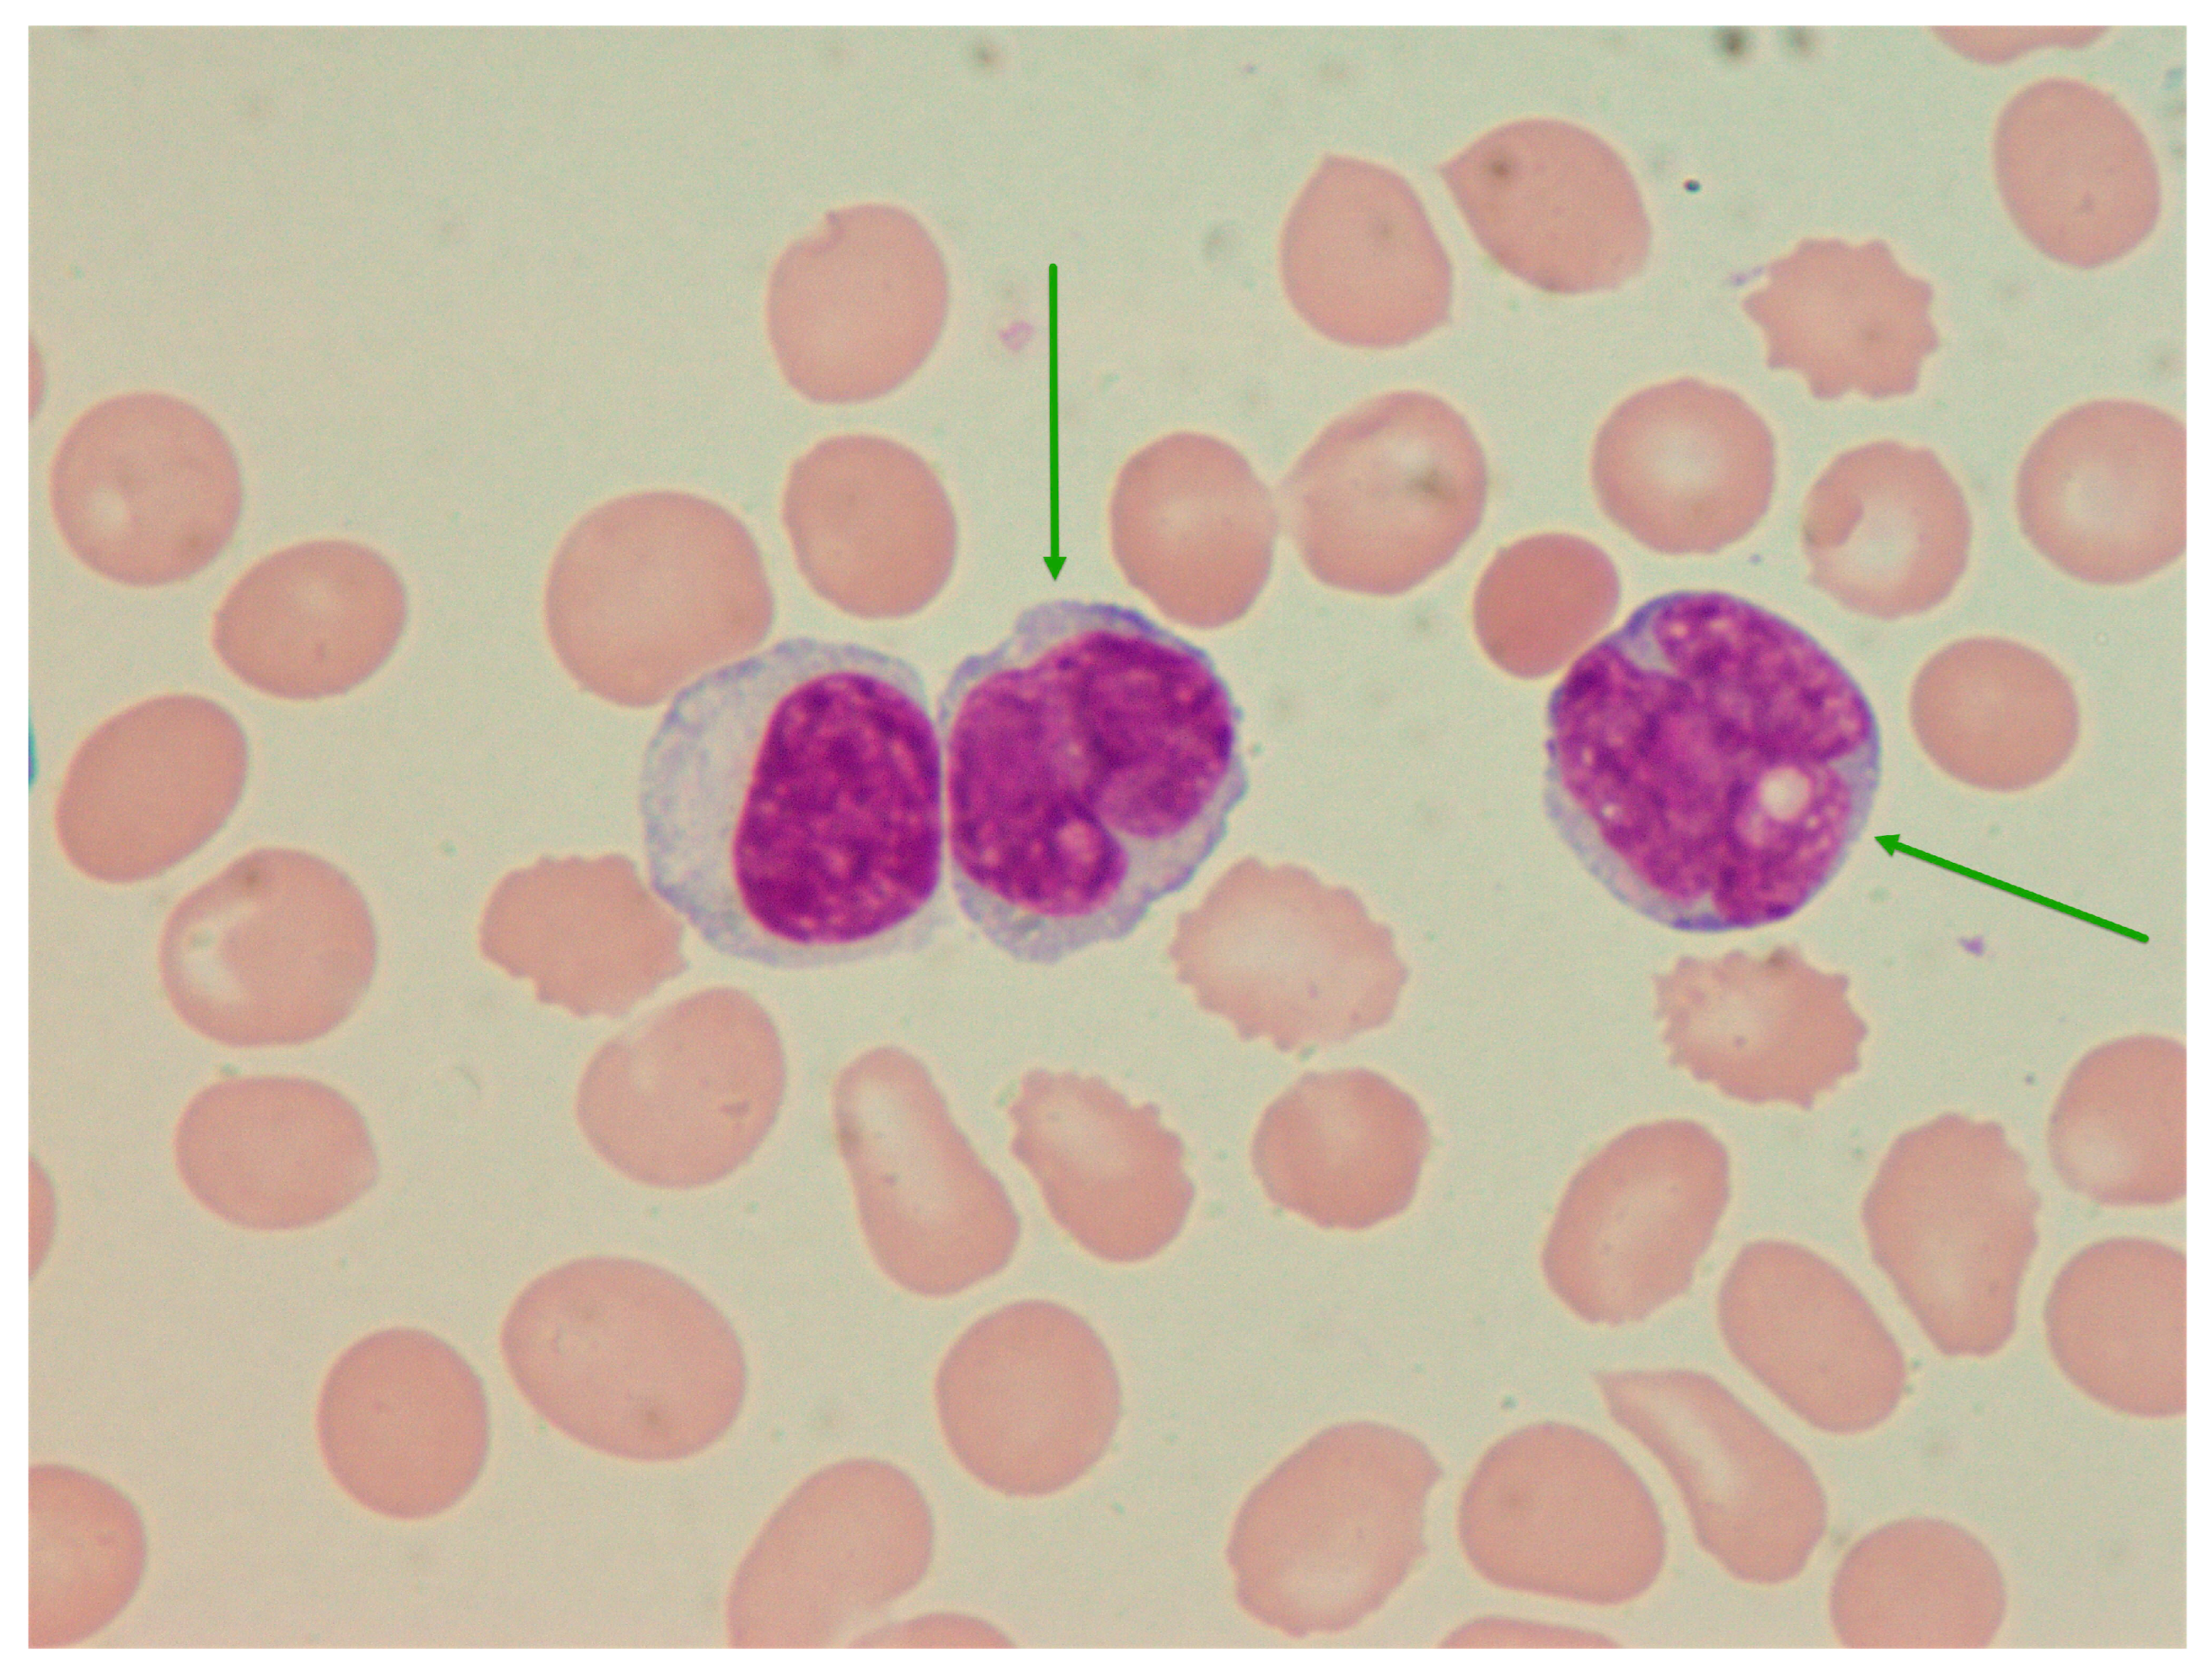
Medicina 60 01351 g001

Atypical Plasma Cell Leukemia Mistaken for Acute Leukemia: A Case Report
Abstract
1. Introduction
2. Case Report
3. Discussion
4. Conclusions
Author Contributions
Funding
Institutional Review Board Statement
Informed Consent Statement
Data Availability Statement
Conflicts of Interest
References
- Musto, P.; Statuto, T.; Valvano, L.; Grieco, V.; Nozza, F.; Vona, G.; Bochicchio, G.B.; La Rocca, F.; D’auria, F. An update on biology, diagnosis and treatment of primary plasma cell leukemia. Expert Rev. Hematol. 2019, 12, 245–253. [Google Scholar] [CrossRef] [PubMed]
- Sant, M.; Allemani, C.; Tereanu, C.; De Angelis, R.; Capocaccia, R.; Visser, O.; Marcos-Gragera, R.; Maynadié, M.; Simonetti, A.; Lutz, J.-M.; et al. Incidence of hematologic malignancies in Europe by morphologic subtype: Results of the HAEMACARE project. Blood 2010, 116, 3724–3734. [Google Scholar] [CrossRef] [PubMed]
- Gimsing, P.; Holmström, M.O.; Klausen, T.W.; Andersen, N.F.; Gregersen, H.; Pedersen, R.S.; Plesner, T.; Pedersen, P.T.; Frederiksen, M.; Frølund, U.; et al. The Danish National Multiple Myeloma Registry. Clin. Epidemiol. 2016, 8, 583–587. [Google Scholar] [CrossRef] [PubMed]
- Fernández de Larrea, C.; Kyle, R.; Rosiñol, L.; Paiva, B.; Engelhardt, M.; Usmani, S.; Caers, J.; Gonsalves, W.; Schjesvold, F.; Merlini, G.; et al. Primary plasma cell leukemia: Consensus definition by the International Myeloma Working Group according to peripheral blood plasma cell percentage. Blood Cancer J. 2021, 11, 192. [Google Scholar] [CrossRef] [PubMed]
- Kraj, M.; Pogłód, R.; Kopeć-Szlezak, J.; Sokołowska, U.; Woźniak, J.; Kruk, B. C-kit receptor (CD117) expression on plasma cells in monoclonal gammopathies. Leuk Lymphoma 2004, 45, 2281–2289. [Google Scholar] [CrossRef] [PubMed]
- Kraj, M.; Kopeć-Szlęzak, J.; Pogłód, R.; Kruk, B. Flow cytometric immunophenotypic characteristics of 36 cases of plasma cell leukemia. Leuk. Res. 2011, 35, 169–176. [Google Scholar] [CrossRef] [PubMed]
- García-Sanz, R.; Orfão, A.; González, M.; Tabernero, M.D.; Bladé, J.; Moro, M.J.; Fernández-Calvo, J.; Sanz, M.A.; Pérez-Simón, J.A.; Rasillo, A.; et al. Primary plasma cell leukemia: Clinical, immunophenotypic, DNA ploidy, and cytogenetic characteristics. Blood 1999, 93, 1032–1037. [Google Scholar] [CrossRef] [PubMed]
- Nandakumar, B.; Kumar, S.K.; Dispenzieri, A.; Buadi, F.K.; Dingli, D.; Lacy, M.Q.; Hayman, S.R.; Kapoor, P.; Leung, N.; Fonder, A.; et al. Clinical Characteristics and Outcomes of Patients with Primary Plasma Cell Leukemia in the Era of Novel Agent Therapy. Mayo Clin. Proc. 2021, 96, 677–687. [Google Scholar] [CrossRef] [PubMed]
- Katz, R.L. Cytologic diagnosis of leukemia and lymphoma. Values and limitations. Clin. Lab. Med. 1991, 11, 469–499. [Google Scholar] [CrossRef] [PubMed]
- Swerdlow, S.H.; Campo, E.; Harris, N.L.; Jaffe, E.S.; Pileri, S.A.; Stein, H.; Thiele, J. WHO Classification of Tumours of Haematopoietic and Lymphoid Tissues. WHO Classification of Tumours, 4th ed.; IARC: Lyon, France, 2017. [Google Scholar]
- Venkatesan, S.; Boj, S.; Sneka Nagaraj, S. A study of clinico-hematological profile in acute leukemia with cytochemical correlation. Int. J. Acad. Med. Pharm. 2023, 5, 893–898. [Google Scholar]
- Sekar, M.D.; Raj, M.; Manivannan, P. Role of Morphology in the Diagnosis of Acute Leukemias: Systematic Review. Indian J. Med. Paediatr. Oncol. 2023, 44, 464–473. [Google Scholar] [CrossRef]
- Khoury, J.D.; Solary, E.; Abla, O.; Akkari, Y.; Alaggio, R.; Apperley, J.F.; Bejar, R.; Berti, E.; Busque, L.; Chan, J.K.; et al. The 5th edition of the World Health Organization Classification of Haematolymphoid Tumours: Myeloid and Histiocytic/Dendritic Neoplasms. Leukemia 2022, 36, 1703–1719. [Google Scholar] [CrossRef] [PubMed]
- Fang, H.; Xu, J. Blastoid plasma cell leukemia mimicking acute leukemia. Blood 2020, 136, 1012. [Google Scholar] [CrossRef] [PubMed]
- Toriyama, E.; Imaizumi, Y.; Tsuruda, K.; Itonaga, H.; Sato, S.; Ando, K.; Sawayama, Y.; Hasegawa, H.; Hata, T.; Niino, D.; et al. Oligosecretory Primary Plasma Cell Leukemia with Atypical Morphological Abnormality. Intern. Med. 2019, 58, 2213–2217. [Google Scholar] [CrossRef] [PubMed]
- Dadu, T.; Rangan, A.; Handoo, A.; Bhargava, M. Primary non-secretory plasma cell leukemia with atypical morphology—A case report. Indian J. Hematol. Blood Transfus. 2009, 25, 81–83. [Google Scholar] [CrossRef] [PubMed][Green Version]
- Pavlovic, A.; Ostojic Kolonic, S.; Radic Kristo, D.; Jelic Puskaric, B.; Kardum Skelin, I. Atypical blast morphology of primary plasma cell leukemia with renal involvement and plasmablasts in urine. Diagn. Cytopathol. 2015, 43, 158–162. [Google Scholar] [CrossRef] [PubMed]

| Patient’s Values | Units | Reference Values | |
|---|---|---|---|
| Erythrocytes | 3.04 | ×1012/L | 3.86–5.08 |
| Hemoglobin | 93 | g/L | 119–157 |
| MCV | 92.3 | fL | 83.0–97.2 |
| Thrombocytes | 51 | ×109/L | 158–424 |
| Leukocytes | 21.90 | ×109/L | 3.4–9.7 |
| Neutrophils | 2.15 | ×109/L | 2.06–6.49 |
| Lymphocytes | 6.53 | ×109/L | 1.19–3.35 |
| Atypical cells | 12.35 | ×109/L | 0 |
| Ig A | <0.2 | g/L | 0.7–4.0 |
| Ig M | <0.2 | g/L | 0.4–2.3 |
| Ig G | 1.2 | g/L | 7.0–16.0 |
| PT | 1.23 | 1 | 0.70–1.40 |
| APTT | 33.87 | s | 25.00–40.00 |
| Fibrinogen | 3.88 | g/L | 1.80–4.00 |
| 1st LINE alternate: VCD (21-day cycle) ×2 | PAD (21-day cycle) ×2 |
| bortezomib 1.3 mg/m2 SC D1, D4, D8, D11 Cyclophosphamide 500 mg IV D1, D8, D15 Dexamethasone 20 mg IV D1, D2, D4, D5, D8, D9, D11, D12 | doksorubicin IV 10 mg/m2 D1–D4 bortezomib 1.3 mg/m2 SC D1, D4, D8, D11 deksametazon 40 mg IV, D1–D4 |
| 2nd LINE: Dd-PACE (28-day cycle) ×2 | |
| daratumumab 16 mg/kg IV D1, D8, D15, D22 cisplatin 10 mg/m2 IV D1–4 doxorubicin 10 mg/m2 IV D1–4 cyclophosphamide 400 mg/m2 IV D1–4 etoposide 40 mg/m2 IV D1–4 Dexamethasone 20 mg IV D1, D2, D8, D9, D15, D16, D22, D23 | |
| 3rd LINE: KRd + bendamustine 28-day cycle ×1 | |
| karfilzomib 20 mg/m2 IV D1–2, 27 mg/m2 D8–9, D15–16 lenalidomide 25 mg PO D1–21 dexamethasone 40 mg IV D1, D8, D15 bendamustine 90 mg/m2 IV D1–2 |
Disclaimer/Publisher’s Note: The statements, opinions and data contained in all publications are solely those of the individual author(s) and contributor(s) and not of MDPI and/or the editor(s). MDPI and/or the editor(s) disclaim responsibility for any injury to people or property resulting from any ideas, methods, instructions or products referred to in the content. |
© 2024 by the authors. Licensee MDPI, Basel, Switzerland. This article is an open access article distributed under the terms and conditions of the Creative Commons Attribution (CC BY) license (https://creativecommons.org/licenses/by/4.0/).
Share and Cite
Seili-Bekafigo, I.; Torlakovic, E.; Grenko Malnar, T.; Damić, M.S.; Prka, Ž.; Matušan Ilijaš, K.; Hadžisejdić, I. Atypical Plasma Cell Leukemia Mistaken for Acute Leukemia: A Case Report. Medicina 2024, 60, 1351. https://doi.org/10.3390/medicina60081351
Seili-Bekafigo I, Torlakovic E, Grenko Malnar T, Damić MS, Prka Ž, Matušan Ilijaš K, Hadžisejdić I. Atypical Plasma Cell Leukemia Mistaken for Acute Leukemia: A Case Report. Medicina. 2024; 60(8):1351. https://doi.org/10.3390/medicina60081351
Chicago/Turabian StyleSeili-Bekafigo, Irena, Emina Torlakovic, Tajana Grenko Malnar, Marija Stanić Damić, Željko Prka, Koviljka Matušan Ilijaš, and Ita Hadžisejdić. 2024. "Atypical Plasma Cell Leukemia Mistaken for Acute Leukemia: A Case Report" Medicina 60, no. 8: 1351. https://doi.org/10.3390/medicina60081351
APA StyleSeili-Bekafigo, I., Torlakovic, E., Grenko Malnar, T., Damić, M. S., Prka, Ž., Matušan Ilijaš, K., & Hadžisejdić, I. (2024). Atypical Plasma Cell Leukemia Mistaken for Acute Leukemia: A Case Report. Medicina, 60(8), 1351. https://doi.org/10.3390/medicina60081351

